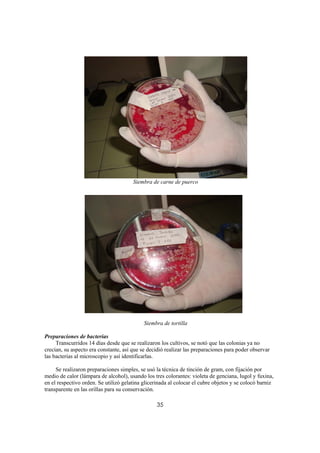
Siembra de carne de puerco




                                            Siembra de tortilla

Preparaciones de bacterias
     Transcurridos 14 días desde que se realizaron los cultivos, se notó que las colonias ya no
crecían, su aspecto era constante, así que se decidió realizar las preparaciones para poder observar
las bacterias al microscopio y así identificarlas.

     Se realizaron preparaciones simples, se usó la técnica de tinción de gram, con fijación por
medio de calor (lámpara de alcohol), usando los tres colorantes: violeta de genciana, lugol y fuxina,
en el respectivo orden. Se utilizó gelatina glicerinada al colocar el cubre objetos y se colocó barniz
transparente en las orillas para su conservación.

                                                  35

El documento trata sobre las bacterias comúnmente encontradas en alimentos contaminados, en particular aquellos vendidos en la calle en ciudades grandes. Describe varias enfermedades gastrointestinales causadas por bacterias, incluyendo intoxicación por estafilococo dorado, salmonelosis, botulismo y enfermedad por Bacillus cereus. Explica los síntomas, tratamientos y formas de prevención de cada enfermedad. El objetivo principal es investigar la presencia de estas bacterias mediante el cultivo de diversos alimentos callejeros.